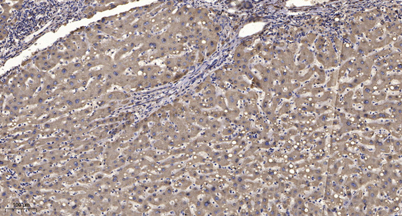

ITPK1 rabbit pAb
 One-click to copy product information
One-click to copy product information$148.00/50µL $248.00/100µL
| 50 µL | $148.00 |
| 100 µL | $248.00 |
Overview
| Product name: | ITPK1 rabbit pAb |
| Reactivity: | Human;Mouse |
| Alternative Names: | ITPK1; Inositol-tetrakisphosphate 1-kinase; Inositol 1; 3,4-trisphosphate 5/6-kinase; Inositol-triphosphate 5/6-kinase; Ins(1,3,4)P(3) 5/6-kinase |
| Source: | Rabbit |
| Dilutions: | WB 1:500-2000;IHC-p 1:50-300; ELISA 2000-20000 |
| Immunogen: | The antiserum was produced against synthesized peptide derived from human ITPK1. AA range:81-130 |
| Storage: | -20°C/1 year |
| Clonality: | Polyclonal |
| Isotype: | IgG |
| Concentration: | 1 mg/ml |
| Observed Band: | 50kD |
| GeneID: | 3705 |
| Human Swiss-Prot No: | Q13572 |
| Cellular localization: | intracellular,cytosol,apical plasma membrane, |
| Background: | This gene encodes an enzyme that belongs to the inositol 1,3,4-trisphosphate 5/6-kinase family. This enzyme regulates the synthesis of inositol tetraphosphate, and downstream products, inositol pentakisphosphate and inositol hexakisphosphate. Inositol metabolism plays a role in the development of the neural tube. Disruptions in this gene are thought to be associated with neural tube defects. A pseudogene of this gene has been identified on chromosome X. [provided by RefSeq, Jul 2016], |
-
 Western blot analysis of lysates from HeLa, HepG2, and Jurkat cells, using ITPK1 Antibody. The lane on the right is blocked with the synthesized peptide.
Western blot analysis of lysates from HeLa, HepG2, and Jurkat cells, using ITPK1 Antibody. The lane on the right is blocked with the synthesized peptide. -
 Western blot analysis of the lysates from HepG2 cells using ITPK1 antibody.
Western blot analysis of the lysates from HepG2 cells using ITPK1 antibody. -
Immunohistochemical analysis of paraffin-embedded human liver cancer. 1, Antibody was diluted at 1:200(4° overnight). 2, Tris-EDTA,pH9.0 was used for antigen retrieval. 3,Secondary antibody was diluted at 1:200(room temperature, 45min).
Immunohistochemical analysis of paraffin-embedded human liver cancer. 1, Antibody was diluted at 1:200(4° overnight). 2, Tris-EDTA,pH9.0 was used for antigen retrieval. 3,Secondary antibody was diluted at 1:200(room temperature, 45min).

 Manual
Manual